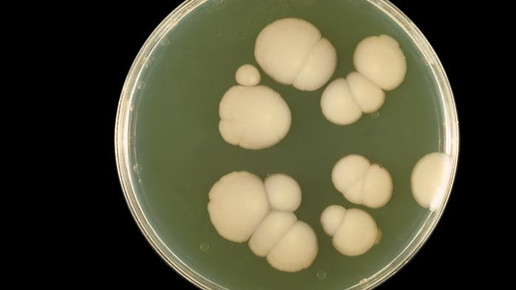
Ratiopharm bringt Anidulafungin

Ratiopharm bringt Anidulafungin
Oberflächliche Candida-Infektionen lassen sich meist gut behandeln. Problematisch und lebensbedrohlich kann jedoch die invasive Candidose sein. Für deren Behandlung bringt Ratiopharm mit Anidulafungin ein Generikum zu Ecalta (Pfizer) auf dem Markt.
Zum 1. Juni listet Ratiopharm das Antimykotikum aus der Gruppe der Echinocandine. Anidulafungin 100 mg ist indiziert zur Behandlung der invasiven Candidiasis bei erwachsenen, nicht neutropenischen Patienten. Hierbei handelt es sich um Candida-Infektionen, die sich in die Blutbahn ausgebreitet haben.
Das Antimykotikum dient somit der systemischen Therapie und wird als Infusion verabreicht. Vor Behandlungsbeginn ist eine Probe für eine Pilzkultur zu entnehmen. Therapiert wird erst, wenn die Ergebnisse vorliegen. Am ersten Tag erhalten die Patienten eine Initialdosis von 200 mg Anidulafungin. Anschließend wir die Dosis auf 100 mg täglich reduziert. Die Therapiedauer richtet sich nach dem individuellen Ansprechen. Entsprechend allgemeiner Empfehlung sollte die Behandlung über einen Zeitraum von 14 Tagen nach dem letzten positiven Kulturergebnis angewendet werden.
Anidulafungin hemmt spezifisch den Zellwandaufbau vieler Faden- und Hefepilze. Die fungizide Wirkung kann auf die Hemmung der 1,3-β-D-Glucansynthese zurückgeführt werden. Das Lipopeptid wird aus einem Fermentationsprodukt von Aspergillus nidulans synthetisiert. Als unerwünschte Arzneimittelwirkungen können beispielsweise Verdauungsstörungen, Flushing oder Kopfschmerzen auftreten.
Caspofungin und Micafungin gehören ebenfalls zu den Echinocandinen. Sie gehören laut Leitlinie neben Anidulafungin und dem Azol Fluconazol zu den Mitteln der ersten Wahl zur Behandlung einer Candidämie und anderen systemischen Candidainfektionen. Pfizer hat mit Ecalta Anidulafungin bereits seit 2007 auf dem Markt.
Das halbsynthetische Lipopeptid Caspofungin wird aus einem Fermentationsprodukt aus Glarea lozoyensis synthetisiert. Der Wirkstoff besitzt die breiteste Indikation der Echinocandine und kann sowohl bei Erwachsenen als auch bei Kindern eingesetzt werden. Dem Wirkstoff werden antimykotische und fungizide Eigenschaften bei Candidamykosen und Aspergillosen zugesprochen. Ratiopharm hat Caspofungin ebenfalls im Portfolio.
Invasive Pilzinfektionen können vor allem bei hospitalisierten Patienten auftreten. Gefährdet sind meist immunsuppressierte, multimorbide oder ältere Patienten. Neben Candida oder Krytokokken zählen auch Aspergillen und Fusarien zu den pathogenen Pilzspezien. In jedem Fall ist ein schneller Therapiebeginn nötig, da sich die Heilungschancen mit jedem Tag, der vergeht, verschlechtern können.

APOTHEKE ADHOC Debatte